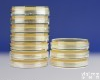
BJ-0011-0666 月桂基<em>硫酸</em>盐<em>蛋白</em>胨肉汤-MUG

硫酸鱼精蛋白价格,硫酸鱼精蛋白
- 产地:中国大陆
- 供应商:上海鼓臣生物技术有限公司
- 供应商报价:电议
- 标签:硫酸鱼精蛋白价格,硫酸鱼精蛋白,生物试剂,生化试剂,供应硫酸鱼精蛋白价格,硫酸鱼精蛋白,上海鼓臣生物技术有限公司
中文名:硫酸鱼精蛋白
英文名:Protamine sulfate
货号:D0023
级别及规格:
| BR,100u/mg | 1克 |
| 5克 | |
| 25克 |
公司成立以来,一直秉着诚信、专业的经营理念为每一位客户提供真诚的服务。我们的服务理念是:做事不离诚信二字,恒古至今,唯有诚信才能赢得的胜利!感谢多年以来全国各个地方的兄弟姐妹们对本公司的大力支持!希望通过我们的不懈努力能为科研事业做出更大的贡献!
公司其他相关产品信息:
| D0023 | 硫酸鱼精蛋白/精蛋白硫酸盐/鱼精蛋白硫酸盐/Protamine sulfate | BR,100u/mg | 1克 |
| 5克 | |||
| 25克 | |||
| D0024 | 兔肌动蛋白/Actin from rabbit muscle | BR,85% | 1毫克 |
| 5毫克 | |||
| 25毫克 | |||
| D0025 | γ-球蛋白(牛)/牛丙种球蛋白/普通丙种球蛋白/γ-Globulins from bovine blood | BR,96- | 1克 |
| 10克 | |||
| D0026 | γ-人球蛋白/人丙种球蛋白/普通丙种球蛋白/human γ-globulin | BR,96- | 250毫克 |
| 1克 |
本公司长期代理sigma货期稳定,美国amresco【全线产品四五折大量现货】,RB原装elisa试剂盒货期稳定【一周时间】,R&D ,abcam, CST ,millpore ,BD ,Merck, Roche ,invitrogen ,qiagen,Millipore等一线品Pai产品,欢迎致电咨询!